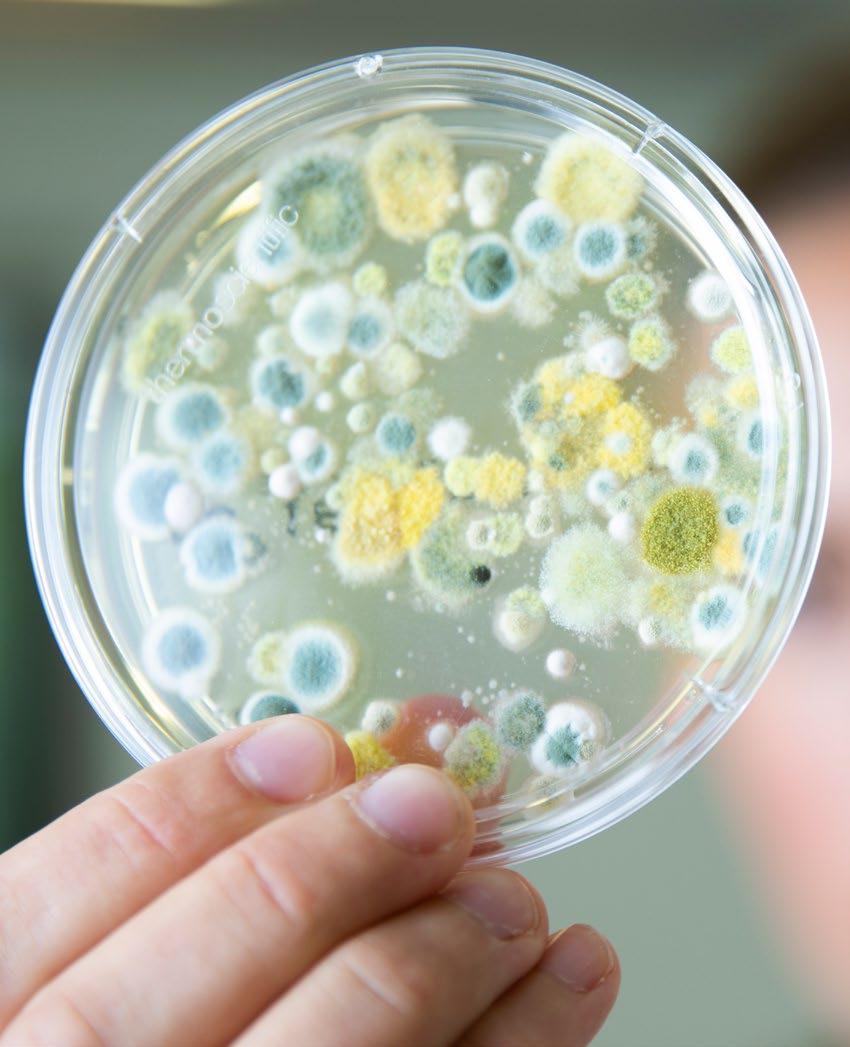

TIDNINGEN

Nyheter för dina smågrisar
Joel Pettersson - Restad Mjölk & Kött AB
SeedSpeed för bättre etablering och högre skörd

![]()

Joel Pettersson - Restad Mjölk & Kött AB

Med YaraMila® MAJS NP 19-8 kan en måttlig fosforgiva placeras tillsammans med hela kvävebehovet från mineralgödsel. Placering av både kväve och fosfor vid sådd ger en hög effektivitet och möjliggör en snabb och jämn etablering, Samtidigt tillförs extra bor och zink som är viktiga för optimal utveckling av majsen.
YaraMila® - Alltid med lågt innehåll av kadmium.





Vi är inne i en omvälvande period i lantbruksbranschen. Strukturomvandlingen som pågått under många år visar sig än tydligare idag. Vi ser det i att många mindre företag har försvunnit, vi ser det i att mark köpts upp av granngårdar eller arrenderas av de samma. Men vi ser det också i nya affärsmodeller som vi inte tidigare sett. Fokus är på att dra nytta av stordriftsfördelar eller en högre produktivitet per hektar eller krona – det gäller att finna lönsamheten, genom att vara uppfinningsrik.
Du som jobbar inom branschen är både kunskapsdriven, erfaren och utbildad i ditt fokusområde som växtodlare eller djurhållare – men du är inte minst affärsman, entreprenör. Du tittar på hur du kan skruva på verksamheten för att göra den både intressantare och lönsammare –för dig och för dina kunder. Du hittar en sidoverksamhet som skapar värde för den primära verksamheten, och som ett sätt att riskstyra.
Det samma gäller för oss som arbetar i handelsledet. Alla större lantbruksverksamheter i Europa lider just nu av lönsamhetsproblem, vilket kräver en översyn av den egna verksamheten. Vad gör vi rätt? Vad gör vi fel? Hur hittar vi ett bättre sätt att möta dagens lantbruk?
I vår egen koncern går vi just nu igenom en sådan förändringsprocess för att ännu bättre dra nytta av vår gemensamma kompetens över länder och företag, samt bättre utnyttja stordriftsfördelar i inköp av bland annat råvaror, insatsvaror och spannmålshandel. Till nytta för det svenska lantbruket, och för lantbrukare i Tyskland och Danmark. Visst finns det skillnader i våra olika lantbrukslandskap, olika förutsättningar m.m. Men mycket är likt, och idéer och utveckling känner inga gränser.
Både våra konkurrenter och vi måste se till att möta dig där du befinner dig i din affärsverksamhet. Det handlar mycket om att förstå
UTGIVNING
Tidningen ges ut av Svenska Foder AB och distribueras i ca 14 000 ex till kunder, rådgivare, skolor, återförsäljare, anställda med flera. Tidningen ges ut 4 ggr/år.
ANSVARIG UTGIVARE
Johan Andersson/Redaktör johan.andersson@svenskafoder.se 010-130 29 84
TEXT & GRAFISK PRODUKTION
INHOUSE Svenska Foder, om inte annat anges.
OMSLAGSBILD
Lotta Hansson, grisfodersäljare i Svenska Foder
Foto: Daniel Ström
vart man tillsammans kan uppnå bäst resultat – en hållbar ekonomi och ekologi. När väl tiderna förändras går det fort, och det är lätt att hamna i bakvattnet av framtiden. Svenska Foder vill fortsätta vara den aktör som du föredrar att göra affärer med på våra meriter – för att vi är kostnadseffektiva, värdeskapande, pålitliga och innovativa. Hur blir vi det?
På ett sätt gör vi som vi alltid gjort: genom att tala med dig, läsa av hur du gör och varför och se hur vi kan möta dig i din affärsverksamhet. I kombination med att skaffa oss kunskap om ny forskning och utveckling samt dela idéer och tankar med våra kollegor i DLG-koncernen kan vi sätta ihop det till ett reellt affärsmannaskap – som satsar långsiktigt på svensk lantbruksnäring.
Carsten Klausen
VD Svenska Foder carsten.klausen@svenskafoder.se
ÖVRIGA BILDER
Svenska Foder AB, DLG och Colourbox, om inte annat anges
TRYCK
Stibo Complete
Johan Andersson, 010-130 29 84 johan.andersson@svenskafoder.se

KONTAKTA OSS
marketing@svenskafoder.se
Växeltel. 0510-828 00
NÄSTA NUMMER
Nästa nr beräknas vara ute v. 51, 2025. /svenskafoder

Strukturrika foder med uppdaterade recept som stödjer hästens tarmhälsa.

LÄS MER OM FIBERGI



Svensktillverkat •Svensk t i l •takrevl krevllitksnevSta •
Fibergi är ett strukturrikt foder som främjar hästens matsmältning.
Den grova strukturen ökar salivproduktionen och gynnar mag- och tarmhälsan.
Samtliga foder innehåller maerl, en kalkalg rik på kalcium och andra mineraler, som hjälper till att buffra magsyror och balansera pH-nivåerna i hästens mage, vilket kan minska risken för magsår hos häst.
Se alla våra foder på www.svenskafoder.se
3. LEDAREN | Strukturomvandling pågår
8. KONCERN | DLG-koncernen fortsätter sin transformation...
12. KONCERN | Frihet under ansvar utvecklar verksamheten
14. 6TOLV | Nyvunna erfarenheter i 6Tolv
17. VÄXTSKYDD | SeedSpeed för bättre etablering och högre skörd
18. VÄXTDOKTORN | Citrongula flaggblad och svarta ax...
22. SPANNMÅL | Håll noggrann koll på din lagrade vara
24. VALL | Är du vår nästa fröodlare?
26. GÖDNING | Fodermajs – beprövad startgödsel lanserad
30. NÖT | Med Fett Balans i mixen
32. NÖT | Provita Protect hjälper kalvtillväxten på traven
34 GRIS | 4 nyheter för dina smågrisar
39. KORSORDET | Facit sommarkrysset

ÖSTERGYLLEN – LÅNG ERFARENHET, EVIGT UNG


FODERVETESORTER TESTAS I 6TOLV

BÅDE LYSANDE OCH UTMANANDE SKÖRDESÄSONG 10
PILOTPROJEKT FÖR ATT DOKUMENTERA EFFEKTERNA AV REGENERATIV ODLING

Under våren började Timmy Lundström sin tjänst som fjäderfäsäljare i Västerlösa. Timmy bor i Motala och har bred erfarenhet från olika branscher.
Närmast kommer Timmy från Klockmasterkedjan, där han ansvarade för marknad och e-handel. Den samlade erfarenheten har gett honom en god förståelse för
företagande, försäljning och långsiktiga kundrelationer.
”Jag ser mycket fram emot att arbeta med fjäderfä inom Svenska Foder. Att få bidra till lantbrukarnas utveckling, skapa värde och bygga hållbara relationer känns både inspirerande och meningsfullt. Med välkomnande och engagerade kunder blir arbetet dessutom väldigt givande.”
På fritiden tycker Timmy om att vistas i skog och natur, gärna i samband med jakt. Han lägger också stor vikt vid att få kvalitetstid tillsammans med sin familj. För Timmy handlar arbetet om mer än försäljning - det handlar om att skapa förtroende, bygga relationer och tillsammans med sina kunder nå goda resultat.

• Marknadens bästa avtal
• Direktkontakt och besök av våra tekniker
• Högklassigt skadedjursskydd
• Låsbara betesstationer i plåt
• Alla åtgärder och besök dokumenteras

Nomus arbetar inom områdena skadedjursbekämpning och brandskydd. Vår verksamhet bygger på kompetens, kunskap, noggrannhet och god service med lång erfarenhet .
Skadedjursavtalet omfattar förebyggande bekämpning, och om olyckan ändå skulle vara framme, så gör våra tekniker en effektiv insats.
MARKNADENS BÄSTA AVTAL www.nomus.se
Genom vår nära anknytning till lantbrukssektorn har vi goda kunskaper inom bekämpning av gnagare, vi utför dimning mm. Vi tillverkar vårt eget rått/ musgift för bästa effekt.
RING 0510-828 00
Medlem i Svenskt Växtskydd. Använd växtskyddsmedel med försiktighet. Läs alltid etikett och produktinformation före användning. Observera alla varningsfraser och symboler. cropscience.bayer.se



Botaniker från Köpenhamns universitet och Wales har identifierat de bästa blomkombinationerna för att locka bin och blomflugor. Genom att granska 400 studier och testa fröblandningar har de utvecklat rekommendationer för att förvandla gräsmattor, parker och uteplatser till livliga pollineringshotspots. De bästa blommorna inkluderar rölleka, rosenskära och blåklint, som både är estetiskt tilltalande och attraktiva för pollinatörer.
Studien visade att fröblandningar med både inhemska och exotiska blomväxter etablerar sig bättre i jorden, blommar längre och besöks av fler pollinerare. Utöver att vara bra för bin och blomflugor, bidrar dessa blomsterstrips även till människors mentala hälsa. Forskarna hoppas att deras resultat kan ge vägledning för de som har trädgård och kommunala trädgårdsmästare när de ska välja växtarter som kan stötta och inspirera pollinatörerna.
Källa: ScienceDaily
Forskare vid University of California, Davis, har utvecklat banbrytande vetesorter som kan stimulera produktionen av sitt eget gödningsmedel, vilket kan leda till betydande minskningar av kväveanvändningen och stora besparingar för bönder världen över. Genom att använda genredigeringsteknologin CRISPR har teamet, lett av professor Eduardo Blumwald, lyckats modifiera vete att producera mer av en bioaktiv förening som finns naturligt i växten kallad apigenin. Denna förening stimulerar kvävefixerande bakterier i jorden att omvandla kväve från luften till en form som växterna kan använda. Den nya vetesorten minskar behovet av kvävegödsel och har visat sig ge högre avkastning än kontrollplantor även med låg koncentration av kvävegödsel.
För bönder i USA, som spenderade nästan 36 miljarder dollar på gödningsmedel år 2023, kan denna innovation innebära enorma besparingar. Professor Blumwald uppskattar att en minskning av kvävegödsel med 10 % på de cirka 500 miljoner hektar som är planterade med spannmål kan resultera i över en miljard dollar i besparingar varje år.
Forskningen har stöttats av Bayer Crop Science och UC Davis Will Lester Endowment, och en patentansökan har lämnats in av University of California. Genombrottet representerar en betydande framgång inom jordbruksvetenskap och kan spela en avgörande roll för att minska miljöpåverkan och kostnader för bönder globalt.


Utmaningar med Enorm Biofactory och en pressad spannmålsmarknad påverkade resultatet som DLGkoncernen levererar under första halvåret. Fokus ligger fortsatt på att förbättra konkurrenskraften inom kärnverksamheten och framtidssäkra koncernen genom transformationsprogrammet ReGen.
Under de första sex månaderna uppgick intäkterna till 42,9 miljarder SEK jämfört med 41,1 miljarder SEK under samma period förra året, medan EBITDA var 1,2 miljarder SEK jämfört med 1,3 miljarder SEK under första halvåret 2024. Minskningen i EBITDA beror på en nedskrivning på grund av rekonstruktionsprocessen vid Enorm Biofactory, samt en utmanande spannmålsmarknad under första halvåret.
En viktig milstolpe under första halvåret 2025 var lanseringen av det treåriga transformationsprogrammet ReGen.
-Vi såg en stabil utveckling över flera kärnverksamhetssegment under första halvåret, vilket understödde rörelseresultatet från vår kärnverksamhet. Resultatet som levererats ligger dock fortfarande under våra ambitioner och potential. Vår huvudsakliga prioritet är att utvinna mer värde genom fokus och förbättrad konkurrenskraft. Därför har vi lanserat ReGen för att framtidssäkra DLG-koncernen genom att öka effektiviteten, stärka konkurrenskraften och accelerera värdeskapandet, säger koncernchef Peter Giørtz-Carlsen och fortsätter:
-2025 är ett övergångsår där vi effektiviserar och investerar i transformationen för att förbättra vår kärnverksamhet. Vi har identifierat vår fulla potential, vår plan är klar och vi är övertygade om att de nuvarande åtgärderna kommer att lägga grunden för starkare och mer stabila resultat i framtiden. En transformation av denna omfattning tar tid och kräver en konsekvent insats. Vi har fullt fokus på att leverera på våra mål och disciplinerat nå dem för att säkerställa värdeskapande för våra ägare.”
Bra start på året inom kärnverksamheten
Inom Agriculture Business Group var prestationen generellt stark även om en utmanande global spannmålsmarknad under första halvåret hade negativ påverkan. Svenska Foder och DanÆg hade en bra start på året och Animal Nutrition Business Group (Vilofoss) levererar solida resultat.
Energy Business Group levererade ett stabilt resultat, även om affärsmixen förändras på grund av förändrade, volatila marknadsförhållanden. Housing Business Group stabiliserar resultatet efter ett utmanande 2024 och fokuserar sina insatser på att justera verksamheten till nya marknadsrealiteter under första halvåret.
-Det är positivt att de flesta av våra kärnaktiviteter levererar på sina mål, medan de primära utmaningarna under första halvåret kommer från våra icke-kärnaktiviteter. Att stärka vår kärnverksamhet förblir en viktig strategisk prioritet,” säger Peter Giørtz-Carlsen.
Utsikter för 2025
-Även om vi ser vissa positiva utvecklingar i vår kärnverksamhet och att skördeutbytet ser ut att öka över hela Europa, ser vi också att spannmålsmarknaderna fortsätter att pressas av fortsatt låga priser. Dessutom är vi i ett övergångsår där vi vänder på varje sten med vårt ReGen-program för att göra DLG Group redo för framtiden, och detta arbete kommer med ytterligare kortsiktiga justeringar. Baserat på detta förväntar vi oss att 2025 blir ett utmanande och otillfredsställande år ur ett ekonomiskt perspektiv. Våra fortsatta ansträngningar är nödvändiga för att skapa grunden för starkare och mer stabila resultat i framtiden. Vi kommer att hålla vårt fokus på att stärka vår kärnverksamhet och säkerställa att transformationen fortsätter att bygga långsiktigt värde, säger Peter GiørtzCarlsen.
-Vi har identifierat vår fulla potential, vår plan är klar och vi är övertygade om att de nuvarande åtgärderna kommer att lägga grunden för starkare och mer stabila resultat i framtiden.
Peter Giørtz-Carlsen Koncernchef DLG

Under de senaste två åren har DLG-koncernen arbetat för att främja regenerativt jordbruk, och nu tar kooperationen ytterligare ett steg genom att samla 10 utvalda jordbruk i ett pilotprojekt som ska samla in data och beräkna effekterna på odlingsmetoden.
-En sak är att vi kan se och känna med våra egna ögon och händer att jordkvaliteten förbättras när man odlar regenerativt. Men vi behöver också data på fältnivå för att kunna dokumentera fördelarna med den regenerativa odlingsmetoden, så vi därigenom kan skapa värde för våra ägare, lantbrukarna.
Det säger Claus Stig Pedersen, Executive Vice President i DLG Group, då företaget meddelar att de nu tar nästa steg i att dokumentera effekterna av regenerativ odling.
Data ska ligga till grund för beräkningar
I ett pilotprojekt, kallat 'DLGreen', kommer DLG att samla in och bearbeta aktivitetsbaserad data från 10 delägare, vilket ska ge en bättre förståelse av de miljö- och klimatmässiga fördelarna som är förknippade med odling enligt regenerativa principer. Samtidigt ska dessa data ligga till grund för verifiering av fördelarna enligt den standard som efterfrågas av de stora livsmedelsproducenterna på marknaden.
En rapport gjord av Boston Consulting Group för Food Nation Denmark har tidigare uppskattat att Danmark kan minska sina CO2-utsläpp med omkring 10 procent om jordbruket brett övergår till regenerativ odling. Därför är potentialen stor.
-Vi vet att det finns något att hämta här, men vi behöver data och dokumentation för att möta den nuvarande och framtida efterfrågan på marknaden och generera värde genom hela värdekedjan. Det är ett viktigt arbete vi sätter igång nu, säger Claus Stig Pedersen.
Projektet löper över flera år, där olika grödor ska introduceras så att det till slut finns en fullständig växtföljd på de enskilda gårdarna, och data samlas in för alla grödor. Baserat på resultat och lärdomar från datapilotprojektet kommer DLG samtidigt att uppmuntra och introducera fler delägare till att odla enligt de regenerativa odlingsmetoderna och rapportera in i datamodellerna.
När data och dokumentation väl är etablerad, kommer den att göras tillgänglig för dryck– och livsmedelsproducenter och som vill kunna dokumentera hur de förbättrar miljöprofilen av sina produkter och aktiviteter genom att främja de regenerativa odlingsmetoderna.
Definition av regenerativt jordbruk Under de senaste åren har flera lantbrukare börjat odla enligt regenerativa principer, och DLG har bjudit in till diskussioner med olika led i värdekedjan för att kartlägga hur branschen gemensamt kan främja odlingsformen.
År 2024 inledde DLG också ett samarbete med Carlsberg om leverans av maltkorn som odlas enligt regenerativa principer, och år 2025 odlas regenerativt maltkorn på mer än 50 jordbruk.
-Regenerativ odling är ett av de hetaste ämnena inom växtodling just nu, säger Claus Stig Pedersen. Vi ser en potential där det finns fördelar att hämta för klimatet, miljön och näringslivet – och som samtidigt öppnar nya vägar för att utveckla vår kärnverksamhet till nytta för ägarna. Men för att säkerställa en stark och sammanhängande värdekedja behöver vi ha dokumentationen på plats, och det är just det arbetet vi nu sätter igång.
Under den första tiden har många efterfrågat tydliga definitioner på vad regenerativt jordbruk är. Internationellt har fler och fler i branschen börjat följa den så kallade SAI-standarden, som ställer krav inom fyra områden: Jordhälsa, vatten, biodiversitet och klimat.
DLG Groups nya pilotprojekt bygger vidare på SAI:s definitioner, samtidigt som erfarenheterna från Carlsberg-samarbetet om maltkorn integreras.
-Det är uppmuntrande med det stora intresset bland våra delägare och den fortsatt växande efterfrågan på den danska marknaden, säger Claus Stig Pedersen. Och det är särskilt uppmuntrande att några av världens största företag, som Walmart och Nestle, i allt större utsträckning efterfrågar regenerativt odlade råvaror i sina försörjningskedjor. Det gläder oss, för vi behöver få ännu fler branscher och stora företag med, för att lantbrukaren ska kunna odla regenerativt år efter år på större arealer - och få hela växtföljden med i denna typ av odling, säger Claus Stig Pedersen.
-Vi vet att det finns något att hämta här, men vi behöver data och dokumentation för att möta den nuvarande och framtida efterfrågan på marknaden och generera värde genom hela värdekedjan. Det är ett viktigt arbete vi sätter igång nu.


Claus Stig Pedersen är nybliven Executive Vice President för Hållbarhet och Kommunikation och började i DLG-koncernen i 1 juni i år. Han kommer närmast från Deloitte där han är delägare och nordisk hållbarhetschef. Han har en Master of Science och en fil. Doc. från Danmarks Tekniska Universitet och har arbetat med affärdriven hållbarhet i mer än 30 år. Han har tidigare varit chef för Global hållbarhet hos Novozymes och Hållbarhet och Kvalitet hos Hartmann Packaging.
Sebastian Karlsson är nyanställd skadedjurstekniker i Nomus, Svenska Foders dotterbolag. Nomus är en kvick och nytänkande aktör som jobbar med skadedjursbekämpning och brandskydd mot lantbruks-, industri-, livsmedelssektor samt fastighets- och försäkringsbolag. Tidningen stämde träff med Sebastian för att höra hans första reflektioner kring sin nya arbetsgivare.
Sebastian har också i en tidigare anställning arbetat inom skadedjurssektorn, och har erfarenhet av att hjälpa kunder med olika problem som man stöter på i sin vardag. Men han ville se sig om, och hade en före detta kollega i Kevin Thorsén - som även han jobbar i östra delarna av landet – som tipsade Sebastian om en öppning. Den 1 juni i år började hans sin anställning.
-Kevin och jag jobbade bra ihop tidigare, och när Nomus sökte ytterligare en tekniker i området, sökte jag och fick möjligheten.
Grannar pratar med grannar
Sebastian är inne i en etableringsfas så här i början av sin anställning.
Just nu handlar det mycket om att skaffa sig en överblick om kunderna som redan finns och de som kan bli nya kunder. Det handlar om att ta mycket kontakter, visa upp sig och berätta om Nomus styrka: den personliga servicen.
-Jag och Kevin diskutera mycket hur vi ska lägga upp arbetet, och jag får mycket stöd av honom och vi bollar idéer på hur jag ska ta mig vidare. Mycket handlar om att bygga nätverk i det område jag verkar och se till att vara en problemlösare för mina kunder. Om jag kan bidra till att lösa ett problem för mina kunder, då har jag snabbt fler kunder på tråden. Grannar pratar med grannar.
En schweizisk armékniv Lantbruket är en stor kundgrupp för Nomus – delvis via ägaren av bolaget, Svenska Foder. Det finns en djup kunskap och stor förståelse för de problem som lantbruket brottas med fällande skadedjursbekämpning, desinfektion och bekämpning av insekter i hönshus osv. Men man jobbar också mot olika typer av industrier, samt brandskydd och mot hamn och fartyg.
-Nomus är en schweizisk armékniv med många olika funktioner, eftersom fokus ligger att hjälpa kunderna. Råttor, möss och skadeinsekter är ju något som bolaget jobbat mycket med och har lång erfarenhet av, men vi har också sett ett stort behov hos våra kunder av att försöka hjälpa våra kunder med andra typer av problem – som fåglar, t.ex.
-Det här är såklart inte ett lätthjälpt problem och det beror alldeles på situationen hur man kan jobba för att få bort förmycket fåglar. Men det finns strategier och metoder.
-Jag har jobbat en del med detta i mitt förra arbete, mycket mot mås och duva, berättar Sebastian. Men även mot andra skadefåglar. Det är viktigt att noga analysera problemet på plats och göra sig en uppfattning om hur stort problemet är, och sedan göra en plan för hur man bäst går tillväga.
-Det är den intressanta och utmanande delen av arbetet, och ibland kan det såklart vara alldeles för utmanande och man får tacka nej. Men tillsammans med kunden kan man oftast göra upp en realistisk plan, och sen gå metodiskt tillväga med olika typer av hjälpmedel och strategier för att få bukt med problemet.
Utvecklas med kunden Sebastian menar att Nomus är ett företag som gärna vill utvecklas med sina kunder och att det är det stora lilla företagets styrka: flexibiliteten.
-För mig handlar om trovärdighet och att läsa av marknaden på rätt sätt, säger han. Att inte bara sälja på någon ett avtal, utan att lyssna av vad vi faktiskt kan hjälpa till. Kan vi förstå våra kunders olika behov kan vi också möta dem där de befinner sig och göra det vi är bäst på: problemlösning. På så sätt skapar vi verkliga relationer, som kan leda till långa åtaganden och långsiktiga affärer. Och nöjda kunder.
Jag får tag på VD Roger Valkegård för att höra vad han har att säga om hur Sebastian ser på bolaget under sina första månader.
-Det är såklart kul att höra, säger Roger. Men jag tror det är helt nödvändigt för alla företag. Ska man vara aktuell på en marknad, måste man visa sig kapabel och vara öppna för nya vägar och områden. Vi utför en service för våra kunder och löser problem.
-Problemlösning kan se ut på olika sätt och kan vara olika saker, beroende på att våra kunders verksamheter ser väldigt olika ut. Genom att ha medarbetare som är lösningsorienterade och kreativa får man nya idéer in i företagandet. Då skapar vi förutsättningar för att utvecklas tillsammans med våra kunder, avslutar han.

Nomus Skadedjursbekämpning och Brandskydd arbetar inom lantbruks-, industri-, livsmedelssektorn och med fastighets- och försäkringsbolag. Vår verksamhet bygger på kompetens, noggrannhet och god service. För att minimera dina skador och problem inom miljö och hälsa arbetar vi med förebyggande och uppföljande verksamhet. Nomus personal har många års erfarenhet inom branschen: engagerade servicetekniker som vet vad de talar om. De gör alltid ett noggrant och säkert arbete med en ordentlig uppföljning.
Är du intresserad av ett skadedjursavtal?
I vårt avtal ingår:
• Marknadens bästa avtal
• Direktkontakt och besök av våra professionella tekniker
• Högklassigt skadedjursskydd
• Låsbara betesstationer i plåt
• Alla åtgärder/aktiviteter och besök dokumenteras på ”Mina sidor”

Under 2025 års säsong har 6Tolv-projektet återigen provat att så maltkorn på hösten. På två gårdar, Landén Agro, och Bjällerups Maskinstation, gjorde man återigen försök med vårkornssådd på hösten.
Försöken grundar sig i diskussioner kring de klimatförändringar som man upplevt och att vårsådd av korn inte har gett några vidare resultat. -Vi har upplevt att vårkornet inte riktigt lyckats leverera några vidare resultat, de senaste åren, säger Per Landén, Landén Agro på Charlottenlunds gård utanför Ystad. Försommartorka efter sådden har blivit allt vanligare hos oss, på ett sätt som vi inte tidigare har upplevt.
Charlottenlund provade redan 2022 att höstså vårkorn. Det var en tuff vinter med minus 15 grader då det var som kallast. Ändå gav det höstsådda fältet 1 000 kilo mer per hektar jämfört med det vårsådda – och dessutom höll det rätt proteinhalt.
-Förra säsongen blev det ingen sådd av vårkorn på hösten, det var en alltför blöt höst och vi kunde inte komma ut och så, säger Max Landén. Om man vill testa att så vårkorn på hösten är det som alltid viktigt att tänka igenom när man ska så, hur väderleken ser ut just då, och vilken växtföljd man tänker sig. Mats Kilany spekulerar:
-Tidpunkten är viktig vid höstsådd av vårkorn, säger Mats. Man vill inte att kornet ska hinna bestocka sig innan vintern kommer. Då blir plantan allt för frostkänslig – och det kan man inte riskera. Så man måste så sent, och då gärna efter sockerbetor eller majs.
Varför då? Sockerbetor och majs är just grödor som kan hålla mer vatten vid tröskningen, och det kan innebära att vårkornet sås i ganska torr jord.
Årets sådd på Bjällerups mark utanför Lund och på Charlottenlunds gård utanför Ystad, skedde vid samma tidpunkt: 18 november 2024.
Bjällerups Maskinstation
Ola Drevås som driver Bjällerups Maskinstation testade även samtidigt att så vårvete och höstvete samma dag – på samma fält.
-Under vårvintern var vi rätt oroliga för vårkornet eftersom temperaturen sjönk till 12 minus under enstaka nätter, säger Mats Kilany. Då såg grödan väldigt medtagen ut och en del plantor utvintrade mycket riktigt.
-Men när det återigen började växa blev bestockningen väldigt kraftig, som i sin tur resulterade i en mycket kraftig gröda, fortsätter han.
Slutresultatet för vårkornet, Laureate, som såddes i november på Bjällerup maskinstations marker blev mer än godkänt: 10 720 kg/ha. Proteinhalten landade på 10,7 och rymdvikten blev 642, med en vattenhalt på 13,9 %. Med en kvävegiva under säsongen på 145 kg/ha.
Dock gick det sämre med höstvetet som såddes lika sent – och likaledes vårvetet var inget att jubla åt. Ola Drevås odlade också SU Joran under året, på vanligt vis, och det gav en toppskörd på 11 600 kg/ha, med en proteinhalt på 11,9 %, rymdvikt på 790 och vattenhalt på 15 %.
Landén Agro, Ystad Hos Landén Agro såddes i år 20 hektar vårkorn, KWS Thalis, 2024 direkt efter sockerbetor.
-Det var en väldigt stabil höst i fjol, säger Max Landén. Inte mycket regn och under vintern hade vi som kallast 9 minus, och även om vi inte hade snö, har vi inte sett några problem med övervintringen.
Slutresultatet landande på 9 700 kg/ha, 9,5 % i proteinhalt och 15 % i vattenhalt.
-Vårt fält med SU Hyvega, hybridvetet, som vi testade i år landade på en avkastning på 12 400 kg/ha, en proteinhalt på 12,3 och en vattenhalt på 14 %.
Bra växtodlingsår gav mindre tydlig skillnad De skillnader i skörderesultat för höstsått kontra vårsått vårkorn som man gjort tidigare år har mindre tydliga denna gång. Årets väderlek har varit gynnsam för de flesta grödor.
-I år var odlingsförhållandena väldigt goda i nästan hela landet, säger Mats Kilany. Odlingsförhållandena har varit exceptionellt bra på de flesta håll, skördarna goda.
Resultaten av det höstsådda vårkornet har också varit riktigt bra. Men eftersom resten av odlingen är likvärdig, blir fördelarna med att så vårkorn på hösten blir mindre tydliga.
-Det är när plantan stressas under en torr vår, som ett bättre utvecklat rotsystem kan göra den stora skillnaden för skörden till hösten, konstaterar Mats. Ett bättre rotsystem gör att plantan kan ta upp både

vatten och näring bättre, trots stress, och kan ge en stabilare tillväxt med större chans till bra proteintal.
6Tolv kommer att fortsätta att göra sina tester kring vårkornet på hösten, och Mats Kilany uppmanar fler till att testa.
-Ju fler som vill testa det här, desto mer underlag och erfarenheter får vi – som kan hjälpa oss framöver, så att vi står beredda när klimatförändringarna blir än mer tydliga.
6Tolv började 2014 som ett projekt i Svenska Foder där målet är att driva upp skördarna genom att tänka kreativt kring vete- och rapsodlingen.
Målet är 6 ton raps, 12 ton vete. Det blev ett projekt som lät talas om sig. Engagemanget var stort. Det var ett omfattande arbete som gjordes bland de lantbrukare över hela landet som deltog, samt de säljare och säljchefer i Svenska Foder som var engagerade.
Nu kör vi projektet – på två gårdar i Skåne: Charlottenlunds gård utanför Ystad och Bjällerups maskinstation – och fortsätter att fokusera och testa nya möjligheter för att uppnå bättre och mer hållbara resultat i växtodlingen.


Under hösten kommer 6Tolv att göra egna försök med hybridvetesorten SU Hybingo och fodervetesorten
Bohr. Dessa kommer att göras i Skåne hos Bjällerups Maskinstation och i skrivande stund hos en lantbrukare i Östergötland.
I årets skånska sortförsök ligger sorterna hybridsorterna SU Hyvega och SU Hybingo i topp. Det är första gången man har med hybrider i försöken. Fodervetesorten Bohr levererar också kanonresultat.
-SU Hybingo har i Skåneförsöken gett en avkastning på 15,3 ton/ha, medan fodervetesorten Bohr som gått mycket bra i Danmark gav 15,1 – också det ett riktigt bra resultat. Vi vill testa de här sorterna, som är fodervetesorter, för att kunna få en idé hur man bäst jobbar med sorten ute i fält – och hur man når bäst resultat.
-Det här är ju till skillnad från SU Hyvega, sorter för de som odlar till sin egen djurproduktion. Sorter där man inte behöver tänka på proteinhalt, utan istället kan koncentrera sig på avkastningen. Det är viktigt och intressant att titta närmare även på dessa sorter – sorter som verkar ha tagit ett rejält kliv upp i avkastning.
Egenskaper som står ut Nu är det viktigt att undersöka hur vi i praktiken kan bibehålla höga skördar även under sämre förhållanden. Hybridhöstvete SU Hybingo tillhör nya generationens hybridvete som har en stark groningskraft. Hybridvetesorterna har ett djupare rotsystem, en snabbare plantutveckling, en bättre bestockning och ett större ax.

-Det här är egenskaper som kan ge oss högre och stabilare skördar till en förbättrad kvalitet, säger Mats.
Bohr – en framtidssort?
Bohr är en annan sort som 6Tolv kommer att testa. Bohr är danska förädlingsföretaget Sejets - del i DLG-koncernen - största höstvetesort med mycket höga avkastningstal i årets Skåneförsök med en avkastning på 15,1 ton/ha och ett relativtal på 114.
-Bohr har många goda egenskaper. Sorten är kärnfrisk genom sin resistens mot vetets viktigaste sjukdomar: gulrost, septoria, brunrost och mjöldryga. Bohr är också resistent mot gul vetemyggan. Bohr är en mycket etableringsstark sort med kraftig tillväxt, medellångt strå och god stråstyrka.
-Sorten har också en god övervintringsförmåga, något som gör den lämplig för vårt klimat. Alla de här egenskaperna gör sorten till en spännande kandidat för framförallt foder – men kan nå kvarnkvalitet, beroende på proteinhalt och odlingsförhållanden.
-Det ska bli spännande att följa hur de beter sig i fält på nära håll tillsammans med de lantbrukare som samarbetar med oss, avslutar Mats.
Vad är hybridvete?
Det är en korsning mellan två vetesorter som valts ut för sina specifika egenskaper och jämnhet i att producera frö. Hybriden strävar efter en stark groningskraft som gör plantorna anpassningsbara till alla typer av jord. Detta är mycket viktigt då de även vid osäkra förhållanden som t.ex. klimatstress och högt sjukdomstryck ska kunna bygga robusta och friska plantor med en god sjukdomsresistens. Den starka groningskraften behövs också för att skapa en jämn och stabil avkastning.
Källa: Scandinavian Seed
Svenska Foder startar upp ett samarbete med företaget Nordic Microbes som jobbar med att utveckla mikrobiella biostimulanter till lantbruket som kan ersätta kemiska betmedel utan att tappa i utbyte. Genom att göra en test på två skånska gårdar kan man få en indikation om det kan vara något för den svenska marknaden.
Nordic Microbes utvecklar naturliga, mikrobiella produkter som hjälper till att frigöra jordens näringsämnen till plantan. De hjälper med sina produkter både konventionella och ekologiska lantbrukare att odla motståndskraftiga grödor med högre utbyte.
-Vi startar nu ett samarbete med Nordic Microbes där vi på två gårdar i Skåne kommer att testa produkten SeedSpeed för att se om vi får praktiska resultat som kan göra skillnad, säger Mats Kilany, växtodlingssäljare i Svenska Foder som också driver 6Tolv-projektet i bolaget.
Svenska Foder kommer att testa produkten SeedSpeed som kan användas i alla stråsädarter samt i åkerböna, majs och potatis. SeedSpeed ökar tillväxt i stråsäd på hösten och man får en kraftigare rotutveckling.
-Vi är alltid intresserade av produkter som SeedSpeed eftersom vi tror mycket vinsten med att jobba med just rotutvecklingen, för att på så sätt skapa en robustare planta som kan klara sig bättre under kärvare förhållanden – och som därför ger högre skörd.
-Det som gör produkten intressant ur vårt perspektiv är att de är utvecklade i nordiska väder- och temperaturförhållanden. Det här är a
och o i vår verksamhet. Vi har specifika förhållanden som måste beaktas. Bakterierna som man betar utsädet med har den förmågan att frigöra fastlagt kalium och fosfor i marken vilket bidrar till den snabba tillväxten.
-Dessutom är produkten effektiv vid låga temperaturer så du kan få en större effektivitet tidigt i säsongen, vilket ger en snabbare tillväxt – som i sin tur täcker jorden snabbare med mindre ogräs som följd.
Med den ökade tillväxten kan man både sänka sin utsädesmängd och öka lönsamheten, enligt bolaget.
-De försök som gjorts visar på en skördeökning med mellan 10-15 % för åkerböna, majs och potatis, säger Mats. Stråsäden ger mellan 3-8 % ökning, och vi kommer att koncentrera oss på detta på fyra försöksgårdar – just denna gång.
-Om SeedSpeed levererar som vi tror den gör, bidrar den både med bättre utbyte, bättre miljö och klimat – vilket är intressant för både oss och våra kunder.

Mats Kilany, ansvarig 6Tolv-projektet och Magnus Hammargren, Produktchef Växtskydd är spända på hur de praktiska försöken med SeedSpeed kommer att utveckla sig under året som kommer.

Sedan 2021 har vi i flera fält i juni månad börjat observera citrongula flaggblad som senare resulterade i upprättstående brådmogna svarta ax med sekundära angrepp av sotmögelsvampar (Alternaria, Cladosporium m.fl.). Angrepp av sotmögelsvampar ses alltid vid en tidpunkt då plantorna av någon anledning brådmognar. Kärnorna i de svarta axen är dåligt utvecklade och mycket små.
Vissa år har angreppen varit värre än andra. Det har funnits många olika förklaringar till fenomenet men vi har ännu inte funnit den helt säkra orsaken. Det kan också finnas flera orsaker till fenomenet.
Varför uppstår sådana nya fenomen när vi inte ändrar vid vår odling?
En sak som ändrats är vädret. Vi får fler perioder då det är mycket torrt eller mycket vått, vi ser också att temperaturen ändrar sig och vintrarna blir mildare. Det kan betyda att nya sjukdomar och skadedjur får bättre förutsättningar att utveckla sig.
Vi ser inga skillnader mellan sorter i förekomsten av svarta ax men det finns en tydlig tendens att sår du i början av september istället för i början av oktober är det större risk för svarta ax. Såtidpunkten har alltså en tydlig betydelse och längre växtperiod på hösten ger större risk.
Men svarta ax kan bero på flera saker. En av orsakerna som påpekats är sena angrepp av löss på hösten/vintern som smittar plantan med rödsotsvirus. På grund av den sena smittan ses symptom inte så tydligt på
våren som vid den tidiga höstsmittan och kommer istället till uttryck genom ett gult flaggblad och senare som ett eller flera svarta ax.
Dålig rotutveckling och rotstress kan också vara en faktor som kan uppstå antingen när det är mycket vått eller torrt. Syrefattiga förhållanden eller brist på vatten i vete kan påverka rottillväxten, vilket medför mindre upptag av näringsämnen och leder till nedbrytning av klorofyll. Det kan också medföra bildning av organiska syror och etylen, som påskyndar mognaden.
I flera infekterade fält har sjukdomen Crazy Top också hittats, som har optimala förhållanden när det är mycket vått. Svampen orsakar gula blad, dvärgväxt, kraftig buskning och deformerade ax. Crazy Top antas dock inte vara huvudorsaken.
Man söker fortfarande efter en bakterie eller en svamp som kan ge ett entydigt svar på varför vi här de senaste åren har börjat se gula flaggblad och svarta ax men kanske finns svaret redan i ovanstående flertaliga förklaringar. Vi följer utvecklingen.
Rödsotsvirus: Sena angrepp av löss på hösten/vintern kan smitta plantan med rödsotsvirus, vilket senare visar sig som ett gult flaggblad.
Syrefattiga förhållanden: Kan uppstå när det är mycket vått, vilket påverkar rottillväxten och leder till mindre upptag av näringsämnen.
Brist på vatten: Kan leda till nedbrytning av klorofyll och gulning av bladen.
Sjukdomen Crazy Top: Optimerade förhållanden i mycket vått väder, vilket orsakar gula blad.


Brådmognad av plantor: Citrongula flaggblad resulterar i upprättstående brådmogna svarta ax.
Sekundära angrepp av sotmögelsvampar: Alternaria och Cladosporium: Svamparna bidrar till svarta beläggningar på axen.
Väderförändringar:
Mycket torrt eller mycket vått: Extremväder kan ge bättre förutsättningar för nya sjukdomar och skadedjur att utvecklas.
Mildare vintrar: Skapar förutsättningar för nya sjukdomar och skadedjur.
Såtidpunkten: Att så i början av september istället för i början av oktober ökar risken för svarta ax.
Dålig rotutveckling och rotstress:
Syrefattiga förhållanden: Kan uppstå när det är mycket vått, vilket påverkar rottillväxten och leder till brådmognad.
Brist på vatten: Kan leda till bildning av organiska syror och etylen, som påskyndar mognaden.

Årets spannmålsskörd är en av de tre största under 2000-talet. Branschföreningen Foder och spannmål har prognostiserat den till att vara upp emot 6,1 miljoner ton, och det kan mycket väl stiga, när väl året sammanfattas. Själva skördearbetet var klart på rekordtid eftersom skördevädret var mycket gynnsamt. Men snabbheten och den stora volymen skapar också utmaningar för logistiken.
Foto: Daniel Ström
Stellan Rask i traktorn och Bengt Larsson lagerställeansvarig i Lidköping under skördeperioden.
Victor Ebel, Spannmålschef i Svenska Foder torkar bildligen svetten ur pannan.
-Det har varit optimala förutsättningar för årets skördearbete och med detta har vi fått en stor volym, säger han. Det är ju otroligt glädjande. Vi har otroligt kompetenta spannmålsodlare i det här landet – som verkligen har levererat väldigt fina resultat.
-Det här har ställt höga krav på vår mottagningskapacitet och även för landet i stort, fortsätter Victor. Även våra lantbrukares lagringsförmåga är under ett sånt här år allt för begränsad.
Det är flera parametrar som skapat årets logistiska utmaningar: Alla arter blev klara i princip samtidigt – något som gör att mer plats tas i anspråk ute på Svenska Foders anläggningar för att kunna särhålla arter och sorter på ett korrekt vis. Dessutom har tröskornas kapacitet ökat genom åren, vilket för med sig ett hårdare tryck under kortare period på vår logistik.
-Spannmålsgårdarna har också vuxit arealmässigt medan lagringskapaciteten inte har växt i samma utsträckning, säger Victor. Det gör att vi denna skörd landar vårt fokus extra mycket på export och logistik. Generellt har ju vädret varit med oss, och det är lyckosamt. Men ett år med sämre förutsättningar – vad händer då?
-Det här är något vi i branschen måste fortsätta att tänka kring inför kommande skördar, konstaterar han.
Arbetet med att avveckla skörden på exportmarknaden har varit intensiv, det har fungerat väldigt bra – men trycket är fortfarande hårt för att på ett så bra sätt hantera de volymer Svenska Foder har köpt in.
-Vi har haft Svenska Foders största exporthantering någonsin under denna första inledande period av skörden, och vårt exportprogram kommer fortsatt
att vara stort pågrund av den stora skörd som kommer in. Vi jobbar intensivt på att hitta ännu fler exportavsättningar.
Den internationella spannmålsmarknaden är emellertid under press. Skördarna i hela Europa har varit stora. I Danmark och Tyskland har man dock haft lite problem med kvaliteterna på veteskörden med låga falltal. Baltikum har å sin sida sett låga rymdvikter på sin veteskörd.
-Det här sätter den svenska skörden i ett mycket bättre läge vid exportaffärerna, säger Victor Ebel. Köparna vill såklart ha den bästa varan, och i Sverige levererar vi på det.
-Men trots kvaliteterna ser vi på kort sikt ingen större prisutveckling, eftersom den så kallade skördepressen troligen kommer att vara lite längre än vad vi är vana vid.
Därför är Victors tips som tidigare att inte vänta för länge med att sälja sin spannmålsvolym – i olika kontraktsformer.
-Vi har en problematisk spannmålsmarknad just nu, som baserar sig på höga priser på insatsvaror och låga spannmålspriser. Det är svårt att få ihop såklart. Då blir den enskildes lantbrukarens riskstyrning otroligt viktig.
-En aktiv riskstyrning göra man genom att teckna kontrakt med oss för hålla sig kvar i marknaden och knyta ihop affärerna med sina insatsvaror. Jag råder också att inte vänta för länge med att ta beslut om att sälja, som vi såg blev fallet under början av 2025. Ju närmre nästa års skörd vi kommer desto sämre blir förutsättningar för bättre betalt – och dessutom blir man tvingad att sälja för att kunna göra plats för ny vara. Det gör att man sätts i en dålig position.
-Ett långsiktigt tänkande med blicken mot kommande års skördar, är ett sätt att hålla en riktning som kan leverera en intjäning som blir balanserad över åren.

-Det är flera parametrar som skapat årets logistiska utmaningar: Alla arter blev klara i princip samtidigt – något som gör att mer plats tas i anspråk ute på Svenska Foders anläggningar för att kunna särhålla arter och sorter på ett korrekt vis.
Victor Ebel, Spannmålschef Svenska Foder
Ulf Thorpert har varit med om många spannmålsskördar genom åren, och 2025 går till historien som en av de bättre skördarna på många år. Även skördeförhållandena har varit gynnsamma. Och även om kvaliteter och volymer ser bra ut, höjer han ett varningens finger till de som lagrar sin spannmål.
Foto: Daniel Ström
Läs mer om Optilabs analyser här:

Förutsättningarna för en god skörd var strålande, säger Ulf Thorpert, Laboratoriechef för Optilab. En kall vår och en fin sommar la grunden för en av de bättre skördarna på många år. Själva skörden kom tidigt, var intensiv med stora skördar och bra kvalitet – generellt över landet. De flesta grödorna blev mogna samtidigt i alla våra olika regioner, och det ledde till en rejäl utmaning för spannmålsbranschen i stort.
Som ansvarig för Optilab konstaterar Ulf att det varit tur att de flesta leveranser hållit en lägre vattenhalt, med tanke på de stora volymerna som skulle flyttas.
-De låga vattenhalterna har underlättat mellanlagringen och det har hjälp hela branschen så här långt.
Goda kvaliteter
När det gäller kvaliteten har bakningsförmågan för vete och råg varit bra under hela säsongen. Proteinhalterna har varierat en del beroende på jordmån och gödsling.
-Även grobarheten på maltkornet har hållit sig stabilt och bra, säger Ulf. Det har funnits en viss oro under säsongen för proteinhalten när utbytet blivit så högt ute på fälten, men snitten har trots hög skörd hamnat på godtagbara nivåer. Det är bara vissa leveranser som har hållit något lägre värden. Rensutbytet på maltkorn var lågt i vissa områden, vilket är tecken på en del småkärnighet – men generellt har nivåerna varit bra.
Få problem med toxiner Året har knappt haft några problem med toxiner.
Några fåtal havrepartier som skördats senare i de nordöstra regionerna har legat över gränsvärderna. Detsamma gäller för fusariumnivåerna i maltkornet.
-Vi har endast sett enstaka partier med laxfärgade kärnor i maltkornet, säger Ulf. Havreskörden i sin tur har genomgående haft en fin färg och mängden gröna och grodda kärnor har varit mycket låg. På många håll har havren även varit hög och stråstyv vilket gett en betydligt större andel halm än ett normalt år.
-Dock har ett orosmoment varit mjöldrygan, där cirka hälften av leveranserna har visat förekomst av sklerotier, vilket ställer stora krav på rensningensärskilt nu när gränsvärdet sänkts.
Förrädiskt torr spannmålsvara I skrivande stund är den största delen av skörden bärgad. Nu återstår den mycket viktiga övervakningen av alla lager. Även om spannmålen håller en låg vattenhalt (13-14 %) är risken för återfuktning mycket stor med mögelproblem som följd – man bör vara särskilt uppmärksam nu när många lagrar in sin spannmålsvara på grund av svag prisbild.
-Det vi ser i år, och som vi också sett tidigare år med torr och fin skörd, är att många lantbrukare lagrar in sin skörd direkt från fält utan att blåsa eller torka den, konstaterar Ulf.
-Kontroll av temperatur är oerhört viktig och minsta förändring kräver rundkörning eller torkning av varorna. Allt för att bryta eventuella mögelhärdar, säger Ulf.

-Vi har endast sett enstaka partier med laxfärgade kärnor i maltkornet. Havreskörden i sin tur har genomgående haft en fin färg och mängden gröna och grodda kärnor har varit mycket låg.
Ulf Thorpert, laboratoriechef Optilab

Vi är alltid på jakt efter nya fröodlare! Varför? Vi vill fortsätta ha svenska fröer i våra svenska fröblandningar!
Vill du testa något nytt, utveckla dig själv och din odling? Hör av dig till oss!

Sofie Sonesson som är ansvarig för kontakten med våra fröodlare säger:
-Fröodling är en väldigt rolig och omväxlande odlingsform som handlar om engagemang, planering, struktur – och att vilja göra det lilla extra och få se det i resultatet! Det lönar sig att anstränga sig, helt enkelt.
Vad är viktigt för en fröodlare?
En av grundförutsättningarna för att veta om man kan bli fröodlare är att känna sina fält.
• Vad passar på din mark och hur fungerar en fröodling i kombination med allt annat du odlar?
• Vilka grödor ska du inte ha på vissa lokaler med tanke på jordart och generella temperaturer?
Det här är något du behöver fundera över, men inget oöverkomligt hinder! Det finns alltid en lösning. Man måste bara vara flexibel och nyfiken på att testa!
Skaffa dig ett nytt nätverk
-Mitt förslag - om du är nyfiken på att testa fröodling, säger Sofie – är att välja ut en mindre areal till att börja med och testa på odlingen ett år. Då får du en känsla för vad det är för en typ av odling. Är du
intresserad av växtodling - och det är du om du odlar idag - då är det en jättespännande odlingsform. -Ett tips på hur man kan sätta sig in i odlingsformen, är att träffa andra fröodlare Sveriges Frö- och oljeväxtodlare (SFO), fortsätter hon. Här finns Erfaträffar som du kan gå på, där man nördat ner sig i någon av de arterna som finns att odla. Du får ett nytt nätverk, som kan vara bra på fler sätt än bara för själva fröodlingen.
Engagemang gör det kul att lyckas! Fröodling kräver lagrings- och torkningsmöjligheter på gården. Det behöver dock inte vara av senaste snittet! Istället är ditt engagemang det viktigaste. Du ska vilja veta hur fröet har det. Är det varmt, åk ut och lufta lagret. Hör du fläkten – fungerar den?
-Målet är att få en så homogen vara som möjligt, det ger bäst resultat. Och är du inte uppmärksam på en vara som blir varm, kan det hända mycket!
-Omsorgen och engagemanget i odlingen gör det roligare att lyckas, säger Sofie! Fröodling är verkligen jätteroligt.
-Allt du behöver är en våg, en spann på 10 liter och en termometer som även mäter luftfuktighet. Det finns överallt att köpa!

-Fröodling är en väldigt rolig och omväxlande odlingsform som handlar om engagemang, planering, struktur – och att vilja göra det lilla extra och få se det i resultatet!
Sofie Sonneson
Ansvarig Fröodlingen



Sofie Sonesson
Ansvarig Fröodlingen
Södra Sverige
Tel: 070-654 51 03
Mikael Gustafsson
Växtodlingssäljare
Östra Sverige
Tel: 010-130 29 20


Gabriel Thor
Växtodlingssäljare
Östra Sverige
Tel: 010-130 29 62
Christofer Breman
Växtodlingssäljare
Västra Sverige
Tel: 010-130 29 47

Fodermajs har etablerat sig som en viktig gröda i svenskt lantbruk, särskilt inom mjölkproduktionen. Under 2020talet har odlingen av fodermajs nästan fördubblats och preliminära siffror för 2025 visar att odlingsarealen nu uppgår till 37 300 hektar1. Denna utveckling speglar ett växande intresse för majs som har blivit ett attraktivt komplement eller alternativ till vallfodret, där både dess höga energiinnehåll och stärkelsehalt utgör en värdefull komponent i grovfoderstaten hos många. Foto: Yara
Samtidigt är majs känslig i etableringsfasen. Temperaturen vid sådd måste vara tillräcklig och det grunda rotsystemet gör grödan extra känslig för brist på lättillgängligt kväve och särskilt lättillgänglig fosfor. En snabb och jämn etablering önskas och att tillföra en lämplig startgödsling är en insats som kan bidra med just det. Ett alternativ för startgödsel är YaraMila MAJS NP 19-8, en nylanserad produkt på svensk marknad, som kombinerar kväve och fosfor med mikronäringsämnen i en placerad giva vid sådd.
Stallgödsel som grund – men med anpassad strategi Majsodling sker ofta på gårdar med tillgång till stora mängder stallgödsel. Stallgödsel täcker vanligtvis grödans behov av kalium och till viss del kväve och fosfor. Men näringsinnehållet i stallgödsel varierar och näringen är inte alltid lättillgänglig tidigt på säsongen.
Majsens utveckling är långsam i början - med ett begränsat växtnäringsupptag tidigt. Särskilt fosfor kan vara svåråtkomligt på grund av grödans grunda rotsystem. För att undvika växtnäringsläckage med en alltför stor stallgödselgiva samt förbättra näringsutnyttjandet, bör gödslingen anpassas noggrannt. En måttlig giva stallgödsel på våren som följs av en placerad startgiva med mineralgödsel rekommenderas för att möta behovet av mer lättillgängligt kväve och lättillgänglig fosfor.
Startgiva med fosfor och kväve ökar skörden
En svensk försöksserie genomförd 2007-2009, studerande kväve- och fosforgödsling till majs, visade på hur startgivor med fosfor gav tydlig merskörd – framförallt med fosfor i kombination med kväve. Fosfor eller fosfor och kväve som startgiva sågs också ge en högre ts-halt, vilket sannolikt beror på att tillgången av lättillgänglig näring tidigt i utvecklingen gynnar en snabbare utveckling och tillväxt och ger på så sätt grödan mer tid för mognad2. Fosfor är alltså avgörande för majsens tidiga utveckling - särskilt med tanke på grödans grunda rotsystem. Den svenska försöksserien kunde inte hitta någon tydlig koppling mellan fosfortalet (P-AL) i marken och skörderespons vid startgivor med
fosfor2. Detta pekar just på att tillgängligheten av fosfor - snarare än det totala markinnehållet - är avgörande under majsens etableringsfas. Med fosforns låga rörlighet i marken är placering nära fröet vid sådd betydande för att fosforn ska bli tillgänglig i rätt tid – speciellt om kall väderlek råder vid och efter majsens uppkomst.
YaraMila MAJS NP 19-8 nylanserad på svensk marknad En nyhet för året är Yaras nylanserade produkt YaraMila Majs NP 19-8. Produkten kompletterar stallgödselgivan till majs vid sådd och innehåller både en del lättillgänglig nitratkväve tillsammans med en stor andel lättillgänglig fosfor för optimal starteffekt. YaraMila Majs NP 19-8 tillför därmed de näringsämnnen som saknas eller inte är tillgängliga i stallgödsel för majsen och tack vare placering vid sådd kan en hög näringseffektivitet uppnås med endast en körning.
Utöver kväve och fosfor innehåller YaraMila Majs NP 19-8 svavel, magnesium och även viktiga mikronäringsämnen som zink och bor. Danska försök har visat på skördeökning vid tillförsel av bor, där näringsämnet har stor betydelse för blomning och kolvsättning. Zink stimulerar istället majsens rottillväxt och tidiga tillväxt.
Spara en körning med YaraMila MAJS NP 19-8
Den totala kvävegivan för fodermajs på mineraljord ligger vanligtvis kring 120-150 kg N/ha. Hänsyn ska dock tas till skördepotential, plats, förfrukt och stallgödselhistorik eftersom kväveoptimum kan variera. Den högre kvävegivan på mark med liten tidigare majsodling och därmed mindre stallgödsel och den lägre givan på gamla majsmarker.
I Sverige rekommenderas/körs ofta en standardgödsling där stallgödselgivan kompletteras med en körning med 75-100 kg/ha MAP som därefter kompletteras med en andra körning med Axan (NS27-4) för att nå önskad kvävegiva. Med YaraMila Majs, som innehåller mer kväve, kan oftast en körning räcka för att komma upp till en kvävegiva på 120-150 kg N/ha, samtidigt som fosfor, svavel och mikronäringsämnen tillförs (se tabell 1).
1. Jordbruksverket (2025). Preliminära grödarealer efter storleksgrupp och gröda. År 2018-2025. Jordbruksverket. https://statistik.sjv.se/PXWeb/pxweb/sv/Jordbruksverkets%20statistikdatabas/ Jordbruksverkets%20statistikdatabas__Arealer__Preliminar%20arealstatistik/JO0104C01.px/table/tableViewLayout1/
2. Tell, J., Axelson, U. 2010. Kväve- och fosforgödsling till majs. Försöksrapport 2010 för Mellansvenska försökssamarbetet och Svensk Raps. https://www.ffe.slu.se/Webdata/$serie/03F5R2010Kvaeve-_och_fosforgoedsling_till_majs.pdf


YaraMila MAJS
3. Jordbruksverket (2025). Rekommendationer för gödsling och kalkning 2025. (JO24:10). Jordbruksverket. https://www2.jordbruksverket.se/download/18.1b29a1dd194b2e05896c2950/1741082999053/jo24_10.pdf.
*Organiskt bundet och inte direkt tillgängligt.
**Tillgänglighet svår att uppskatta

Gödsla för framtiden
Det är mullen som försvinner i det moderna jordbruket. Mångfalden och antalet organismer minskar och helheten faller sönder. Daggmaskarna, som vi behöver massvis av, gillar varken syntetiskt gödning eller bekämpningsmedel. Förutom att det är dyrt med konstgödsel så riskerar man alltså att utarma jorden. Men om jorden är "död" så kan man boosta den med hönsgödsel. När daggmaskar, bakterier och svampar trivs igen så har den nedåtgående spiralen brutits. Jorden börjar andas, rötterna utvecklas och vattnet stannar kvar i jorden. Jord ska lukta gott!
Med fjäderfägödsel kan du sänka dina kostnader och samtidigt få en bördigare och mindre torkkänslig jord. Hönsgödsel har unika markförbättrande egenskaper som gör jorden mer lättbrukad. Effekten är långsiktig och gödslar du kontinuerligt bygger du upp livet i jorden.
Kontakta EkoNatur och förbättra din jordstruktur!
Nu när spannmålen ligger i lager finns det inget viktigare för dig än att hålla ordentlig koll på din verkliga plånbok – dina spannmålsvolymer. Det är viktigt att hålla lagrad spannmål, råvaror fri från insekter för det finns ingen avsättning för spannmål som innehåller insekter, förutom möjligen beredning av foder för eget bruk. Om man lämnar insekter ostörda i ett parti spannmål, kommer inom mycket kort tid spannmålen att vara osäljbar för de flesta kunder. Kärnorna kommer att reduceras till ett tomt skal och damm utan näringsinnehåll och mögelsvampar kommer att frodas av värmen och fukten som insekterna alstrar.
Hör av dig till Nomus så hjälper de dig att gasa partier om de blivit infekterade av insekter. Du kan också få hjälp med att bekämpa gnagare. Kort sagt: Nomus har mycket kunnig personal som hjälper dig i din vardag. Ring redan idag! De finns till för dig!

Hög avkastning & kvalitet
Håll koll på dina spannmålsvolymer!

Mjukbladig rörsvingel som funnits med i svenska officiella vallförsök sedan 2016 har under åren i provning visat på en hög avkastningsnivå i kombination med en bra kvalitet. Illiade är en nyare sort som vi presenterade föregående år - en sort med tidig vårutveckling. Sorten har hög avkastning och hög kvalitet och vi har lagt in den i några av våra nya blandningar. Det är en rörsvingelsort som är ett mycket intressant tillskott till vår sortbredd i våra blandningar Rask och Alert.
Rörsvingelns etablering är långsam men väl inrättad har arten en mycket god återväxtförmåga med hög utvecklingshastighet och konkurrensförmåga som gör den dominerande under vallens senare liggtid. Därför bör rörsvingeln styra skördestrategin så att de höga näringskvaliteter som efterfrågas uppnås. En intensiv skördestrategi med rätt tajming är ett krav för att uppnå goda resultat.

Boosta de svaga kalvarna
Perfekt
Smågris Ministart är ett BB-foder som är speciellt anpassat till miniblötfoderanläggningar. Ministart ges i kombination mjölkpulver under de första veckorna. Råvarusammansättningen är noga utvald för att få rätt struktur och en homogen blandning som inte separerar i anläggningen. Smågris Ministart finns även tillgängligt i storsäck!
Svenska Foders BB-foder är sammansatta av bästa tänkbara råvaror som bland annat fiskmjöl, potatisprotein och mjölkprotein. Framtagna för att locka smågrisen att äta tidigt och förbereda grisen inför avvänjning och tillväxt.
Provita Response Paste tillför energi, naturligt råmjölkspulver, probiotiska bakterier, äggpulver och vitaminer. Allt för att ge nyfödda kalvar den boost som ibland kan behövas hos svaga kalvar som t.ex. inte orkar komma igång att dia eller dricka mjölk. Response Paste kan även användas för inköpta kalvar och under perioder av stress som t.ex. vid omgrupperingar.
Response Paste innehåller samma probiotiska bakterier som finns i Provita Protect. Råmjölken kommer från komjölk producerad inom EU och är testad för bl.a. salmonella för att vara trygg och säker att ge.
Response Paste tillför:
• Energi – Högkoncentrerad snabb energi
• Råmjölk – naturliga antikroppar
• Äggpulver – förbättrar passivt immunförsvar
• Probiotisk – frisk tarmflora stimulerar aktivt immunförsvar
• Vitaminer – stärker immunförsvar
Ta även en titt på våra andra Provita produkter: Provita Colostrum och Provita Protect. Läs även reportaget om Restad Mjölk & Kött i Hedekas som använder Provita Protect.

Framtagna för att locka smågrisen att äta tidigt & mycket

-Jag har ökat över 500 kg mjölk på ett år. Det är riktigt bra. Idag har jag kor som mjölkar upp emot 70-80 liter mjölk per ko och dag
Emil Hovbjer bedriver mjölkproduktion i Moholm i Skaraborg. Han och hans fru Maria tog över gården från hennes föräldrar 2008 och har sedan dess målmedvetet utvecklat företaget. Och målen är högt ställda. De har en besättning med 140 Holsteinkor där ett mycket stort fokus läggs på avelsbiten i företaget. Det är både ett intresse men också en långsiktig satsning. Målet är hållbara kor som producerar mycket mjölk.
-Mitt avelsarbete handlar idag framför allt om att rikta in sig på högre fett- och proteinhalter, berättar Emil. När jag väljer tjur tittar jag numera mest på dessa parametrar och väljer bort många andra bitar. Merbetalningen finns idag på fett- och proteinhalt – därför ligger vårt fokus självklart där. Sen handlar det ju dessutom om kons hållbarhet och att de är lätta att mjölka. Man brukar säga att en ko är betalad efter två år, då vill man ju ha kvar den så länge som möjligt. Därför vill vi också ha en stark ko och vi har investerat i hög kokomfort, så att de får förutsättningar att hålla länge.
Mjölkproduktionen har ökat väldigt mycket de senaste åren på gården. Delvis på grund av en förändring i hur han utfodrade korna.
-Jag har en mix som består av gräsensilage, majsensilage, krossad vete och majs, värmebehandlat linfrö samt Svenska Foders Fett Balans. Tidigare gav jag Rosa Fett i robotarna och Protein Balans i mixen.

Men så fick jag tipset av min nötfodersäljare på Svenska Foder, Jens Jonsson, att prova Fett Balans. Nu lägger jag istället Rosa Energi i robotarna och Fett Balans i mixen.
- Det var förra hösten vi började. Jag har ökat över 500 kg mjölk på ett år. Det är riktigt bra. Idag har jag kor som mjölkar upp emot 70-80 liter mjölk per ko och dag, fortsätter han. Ändå håller de hullet, ibland lite för bra. Snittet ligger på 48 och jag vill nå upp till 50. Men jag behöver jobba ännu lite till på att få upp fetthalterna. Nu har jag en idé om att testa att blanda i helsäd i mixen. Jag har fått för mig att det är bra för både magarna och halterna.
Det är sökandet efter den rätta kombinationen av olika insatser som inspirerar Emil.
-Avelsarbete, rätt foder, kokomfort och hållbarhet – alla parametrar är viktiga för att nå det resultat jag vill ha, avslutar Emil. Han är på god väg.
Läs mer om våra Balansfoder

Mängd kor: 140 kor
Ras: Holstein
Avkastning: 14 000 ECM – 14 500 kg mjölk
Mjölkningssystem: 2 Lely-robotar och Vector-utfodring
Mjölken levereras till: Falköpings mejeri
Joel Pettersson driver tillsammans med sin kusin Restad Mjölk & Kött AB i Hedekas som ligger i Norra Bohuslän. De båda kusinernas föräldrar drev gården tillsammans, men då Joel Petterssons pappa gick bort 2012 tog han över ansvaret för sin del. 2023 blev generationsskiftet mellan Rasmus Pettersson och hans familj klart.
-Rasmus har varit med länge i verksamheten så det var ingen större skillnad, berättar Joel. Det enda är att vi nu tillsammans driver gården fullt ut, med hjälp av min farbror som är kvar i verksamheten.
Produktionen består av både mjölk- och köttproduktion.
-Vi har 100 mjölkkor och 50 dikor och föder upp alla djur till slakt själva, säger Joel. Växtodlingen består av 260 hektar åkermark och 50 hektar naturbete.
Det har gått väldigt bra för Joel och Rasmus. De är noggranna i sin produktion, och det har gett resultat. Idag snittar mjölkproduktionen på 14 000 ECM.
-Varje del är viktig att få med sig i produktionen, för att ständigt förbättra sig. Då måste man sätta tydliga mål och sedan göra vad man kan för att nå dem. Det tycker jag vi lyckas med för det mesta.
En sådan variabel i deras produktion som de haft problem med och som de velat hitta en lösning på har varit kalvdiarréer. De fick tipset
av Svenska Foder om produkten Provita Protect - ett tillskott som ger kalven en hög mängd av probiotiska bakterier. Provita Protect är den enda probiotika som är medicinskt licensierad för att förebygga diarré hos kalven.
-Vi har haft lite svårigheter med diarréer och det ger stor påverkan på tillväxt och på framtida produktion. Under en kundträff berättade vår säljare Peter Olsson och Erika Nyström, produktchef för Nöt i Svenska Foder, om Provita Protect. Det lät mycket intressant för vår produktion och vi tog beslut om att testa det. Det var ungefär ett och ett halvt år sedan.
Och produkten använder Restad Mjölk & Kött fortfarande.
-Det har fungerat mycket bra, säger Joel. Den är enkel att ge kalvarna. Produkten ges i munnen med hjälp av en medföljande spruta. Vi väljer att ge full dos direkt när kalven är nyfödd. Det fungerar bäst i vår verksamhet. Man kan såklart också välja att dela upp doserna.
-Kalvarna äter mycket bättre och växer till sig på ett helt annat sätt än tidigare, fortsätter han. De blir inte lika sjuka och hängiga längre, och det påverkar hela tillväxtförloppet. Det här blev extra tydligt, när vi en gång av misstag hade glömt att köpa hem Provita Protect. Då blev det snabbt sämre igen, och vi förstod att det här är något som hjälper oss i produktionen.
Läs mer om våra Provita-produkter



-Kalvarna äter mycket
bättre och växer till sig på ett helt annat sätt än tidigare.
Mängd kor: 100 mjölkkor
Ras: Holstein
Avkastning: 14 000 ECM
Mjölkningssystem: 2 Lelyrobotar
Mjöken levereras till: Arla

Spannmålsskörden är nu avslutad och analyserna börjar bli klara. Det är nu dags för att optimera din foderstat efter årets skörd och se till att dina grisar kan optimera sin potential. Vi har jobbat fram flera nya foder under året som baseras på det nya avelmaterialet – de kommer att kunna leverera just det du vill åstadkomma i din produktion. Vi i gristeamet diskuterar gärna resultat med dig med hjälp av våra nya foder – vi är stolta över vad vi har åstadkommit och nu vill vi bevisa det för dig!
Under året har vi lanserat flera spännande nyheter i vårt fodersortiment för gris. Med våra nya produkter Smågris Superstart, Småmix Driv, Småmix Dunder och Tillväxt Raket erbjuder vi lösningar som ger resultat.
-Oavsett om du prioriterar en kraftfull start, en skonsam avvänjning, kraftfull tillväxt i andra fasen eller maximala resultat, har vi rätt produkt för dig, säger Lotta Hansson, grisfodersäljare i Västra Sverige.
-Samtliga av våra nya foder innehåller mycket smakliga syror, vilket gör att smågrisen gärna äter – samtidigt som de hjälper till att sänka pH i mag- och tarmkanalen. Genom att det här är syrorna är de bästa som finns på marknaden, får du bra utdelning i din produktion.
Detta är vårt mest koncentrerade BB-foder, framtaget för dig med höga krav på resultat.
• Högt innehåll av energi
• Mycket smakliga råvaror
• Hög aminosyranivå
Smågris Superstart är ett kraftfulla BB-foder, särskilt utvecklat för att ge bästa möjliga start. Tack vare noga utvalda råvaror får smågrisen en optimal balans mellan smaklighet, tillväxt och mag-tarmhälsa. Finns även i storsäck.
Ett tillväxtkoncentrat för den som vill ge smågrisarna en trygg skonsam start efter avvänjningen.
• Tillväxtkoncentrat
• Främjar stabil mag- och tarmfunktion
• Noggrant utvalda råvaror med fokus på smaklighet
Småmix Driv är utvecklat för att vara extra skonsamt. De lättsmälta råvarorna maximerar tillväxtpotentialen redan från start. Innehållet av attraktiva syror minskar risken för tarmobalans och skapar goda förutsättningar för tidig avvänjning. I kombination med spannmål får du ett välbalanserat foder som hjälper den lilla grisen att nyttja sin fulla potential.
Ett lågt pH förbättrar fodrets smältbarhet och gynnar upptaget av näringsämnen. Detta i sin tur minskar risken för skadliga bakterier som orsakar diarré.
-Vi har ett mycket flexibelt fodersortiment som gör att du kan styra själv hur du vill styra din produktion – både kostnadsmässigt och produktionsmässigt, säger Linnéa Andersson, grisfodersäljare i Syd. Vi vet hur viktigt det är att ta vara på de specifika förutsättningarna på gården för att kunna uppnå rätt resultat. Vi har fortsatt att utveckla foder med fokus just på olika förutsättningar för att kunna möta våra kunder på bästa sätt – och ge dem valuta för pengarna!
-Nu när spannmålsskörden är avslutad och vi vet hur analyserna ser ut, kan vi hjälpa till att tolka dem och anpassa foderstaten efter just dina förutsättningar, fortsätter hon.
Ett kostnadseffektivt tillväxtkoncentrat framtaget för den andra tillväxtfasen.
• Tillväxtkoncentrat
• Kostnadseffektivt
• Passar den andra tillväxtfasen
Småmix Dunder är noggrant sammansatt med högkvalitativa råvaror och en balanserad näringsnivå och passar dig som vill säkerställa en hög tillväxt. Kombineras med spannmål på gård.
Ett komplett tillväxtfoder för dig som vill maximera tillväxtpotentialen.
• Högt innehåll av aminosyror
• Lättsmälta råvaror
• Berikat med syror

Tillväxt Raket är fodret med det högsta aminosyranivån i vårt sortiment. Kombinationen av lättsmälta råvaror och syror gör att fodret inte bara främjar tillväxt utan även skyddar mot skadliga bakterier och förbättrar grisens näringsupptag
Läs mer om våra Smågrisfoder


Östergyllen är en konstant. Redan 1958 startade den ekonomiska föreningen upp i Norrköping som en konkurrent till Lantmännen och ryktet om deras service, deras tillgänglighet och engagemang har levt kvar under alla år. Idag finns Östergyllen både i Norrköping och Linköping, samt även en gårdsservicebuss som främst riktar in sig mot mjölkbönder och levererar förbrukningsmaterial direkt till gårdarna. Allt görs med samma engagemang för sina kunder.
Östergyllen säljer produkter för lantbruk och landsbygd – allt för djur, lantbruk, trädgård och skogsbruk. Man har en trogen kundkrets, men når även nya kunder ständigt, med sin tillgänglighet, erfarenhet, kunnande och oslagbara service.
Tidningen träffar butikschef Josefine Cederblad som är svår att fånga på plats. Telefonen ringer, kunder strömmar in och vill ha hennes uppmärksamhet och det är en ”busy” tisdag i förskingringen. Tillslut får vi möjligheten att sätta oss ner en stund.
-Jag började min heltidsanställning 2016, berättar Josefine. Jag kände väl till Östergyllen, eftersom min svärfar har en köttdjursbesättning och jag hade jobbat extra med mjölkkor efter min föräldraledighet.
-När jag började var man inne i en fas då man hade en VD för båda butikerna. Men efter några år bestämde man sig för att inte ha VD, utan istället jobba med två butikschefer, en i Linköping och en i Norrköping. 2019 anställdes jag som butikschef för Norrköpingsbutiken.
De båda butikerna i Linköping och Norrköping har idag kontakt med varandra på veckobasis och man gör upp prisbilden tillsammans på de produkter man har gemensamt. Dock har butikerna något skild inriktning, men de tänker tillsammans för Östergyllen-varumärket ska fortsätta ha en hög kvalitetsstämpel.
Sedan Josefine blev butikschef har tiden gått fort. Idag är man ett väl sammansvetsat gäng med tre heltidsanställda förutom Josefine. Den som arbetat kortast tid började 2020. Daniel, Johan, Therese och Josefine – och Klara, som är extra under sommaren - möter kunderna där de befinner sig och vill leverera den bästa servicen till de bästa priserna.
-Vi har en bra bredd i vårt sortiment – det gör oss ibland lite trångbodda, men våra kunder vet att vi vill lösa deras utmaningar på bästa sätt. Det är så vi får våra kunder att återvända. De vet att vi gör det lilla extra för dem.
-Visst önskar jag ibland att butiksytan hade haft lite mer luft, men vi jobbar om det vi kan under olika högsäsonger för att våra produkter ska bli synliga på ett konstruktivt vis.
Josefine började som butikschef året innan pandemin. När pandemin slog ned som en bomb i vårt samhälle, blev det också klart för Östergyllen att en viss lagerhållning är viktig att ha.
-Vi har många återkommande kunder inom lantbruk och skogsbruk –men även inom andra områden. Under Coronan lärde vi oss den hårda vägen att vissa produkter kan vi inte jobba med just-in-time. De ska finnas hemma på hyllorna. Den läxan har vi lärt oss och vi har identifierat de varor hos oss som våra kunder alltid ska kunna hitta hos oss.

-Våra kunder ska visuellt kunna se vad vi har i vårt sortiment, och därmed också
kunna fatta snabba beslut på plats. Det är klart att vi inte kan ha allt på display, och vi i personalen är ju tillgängliga och berättar gärna vad vi har till försäljning. Men vårt sortiment är så pass bra, att det är något vi gärna vill skylta med!
”
Josefine Cederblad Butikschef Östergyllen
Idag har Östergyllen lite mer hyllor, pallställ i foderrummet och har ökat utbudet av foder och tillbehör till utfodring
-Våra kunder ska visuellt kunna se vad vi har i vårt sortiment, och därmed också kunna fatta snabba beslut på plats. Det är klart att vi inte kan ha allt på display, och vi i personalen är ju tillgängliga och berättar gärna vad vi har till försäljning. Men vårt sortiment är så pass bra, att det är något vi gärna vill skylta med!
Dock är kommunikationen med kunderna oerhört viktig, menar Josefin.
-Vi är bra på olika saker i vårt gäng: vallfrö och foder, ensilageplast, slitdelar och reservdelan, och stängselstolp är viktiga delar i vår butik här i Norrköping.
-Men jag och mina medarbetare vet också hur viktigt det är att lyssna av våra kunder. Det finns alltid något de vill ha som de kanske inte hittar någon annanstans. Då ska vi kunna hjälpa till med det. Att vara lyhörd inför våra kunders behov skapar också en god relation, som gör att vi behåller våra kunder – och ryktet sprider sig.
Det är mycket småföretagare som kommer till Östergyllen i Norrköping, lantbrukare och skogsbrukare, det var så allt började. Men även privatpersonerna har hittat hit – och stannar eftersom servicen och bemötandet är outstanding.
-Att kunna rådge våra kunder till vad de ska använda genererar förtroende och vi försöker också ha en viss prisdifferentiering så att olika kunder med olika behov kan hitta rätt produkt för dem, är något vi tänker mycket på.
Svenska Foders och Östergyllens samarbete sträcker sig långt tillbaka i tiden. Och samarbetet är gott.
-Svenska Foder är en pålitlig samarbetspartner för oss, säger Josefine. Det fungerar klockrent med leveranser och våra kunder är mycket nöjda med fodren, vallfröprodukterna och stängselstolpen och alla andra produkterna som kommer från Svenska Foder. Att ha en seriös och duktig leverantör är a och o för en verksamhet som vår, eftersom det hjälper oss kunna leverera kvalitet till våra kunder.

Vill du veta mer? Kontaktaossidag! PierreLindskog•0510-82828 info@ekonatur.se

Vi hämtar din fjäderfägödsel enligt överenskommelse – enkelt, smidigt och året om
www.ekonatur.se








Vinnare i krysset nr 2 2025.
1:a 500 kr Marie Jansson Edespong, Forsheda
2:a 300 kr
Inger Gustafsson, Ullared
3:a 200 kr Maja Mårtensson, Sollebrunn
Vinnarna har meddelats per post!
Adresskälla: Svenska Foders adressregister. Avsändare: Ett magasin för Sv.Lantbruksnäring, Box 673, 531 16 Lidköping




Skanna QR-koden för att ta del av de senaste erbjudandena.






Se hela vårt utbud och köp i butik eller i vår webshop!

Alingsås Jordnära AB • Charlottenberg Charlottenberg Pet Product AB • Ed Autodelar i Ed • Eksjö Eksjö Lantbruksservice AB Eslöv Trollenäs Lantmannaaffär AB • Falköping Djur&Natur • Färgelanda Granans Foder & Natur • Grimslöv Grimslövs Järn& Bygg Göteborg Naturnära Foder i Tuve AB • Kil Wermlands Skogsförråd AB • Laholm Gårdsservice Mjölkman AB • Lidköping Djur&Natur • Mellerud, Djur&Natur Mjölby StallMagasinet AB • Munkedal Munkedals Kvarn • Nossebro Djur&Natur • Nyköping Stigtomta Kvarn AB • Partille Hästson AB • Skara Djur&Natur Skurup Landäng AB • Skövde Djur&Natur • Staffanstorp Djur&Natur • Sundsvall Djur&Natur • Svenljunga Axving AB • Sölvesborg Stallbyggen AB Tomelilla Djur&Natur • Tommarp Järrestads Härads Lantmannaförening • Vallåkra Vallåkra Lantmannaaffär • Vankiva Bröderna Lantz Vara Slättens Foder & Trädgård • Vimmerby Vimmerby Foder AB • Vårgårda Djur&Natur • Åseda Åseda Bygg & Järn Älmhult Carl Nilsson Maskin AB • Örkelljunga Örkelljunga Lantmannaaffär • Östersund Djur&Natur
Se vårt sortiment & handla online på